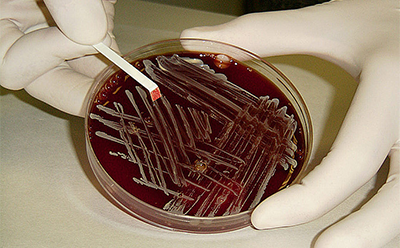
集试纸条、圆片和膜片于一体，使用方便的生化检测试剂盒

微生物识别及生物化学试剂
用于鉴定微生物或区分不同种类微生物的生化、免疫和分子生物学试验,常用于生产设施和学术研究中的微生物质控。这些微生物鉴定试验针对靶细胞的特异性蛋白、某些生化活性(如酶活)或微生物的特征基因序列进行检测。大都在短时间内即可获得重要结果,经济而又易用,而且大多数试验都不需要特殊的设备或仪器。有些生化试验只需在琼脂平板或液体培养基中滴入试剂即可进行。
相关产品资源
鉴定用生化试剂
生化试剂是液体生化试验的基础,用于对目标微生物的酶活特性等进行检测。这种试验通常可在琼脂平板或液体培养基上直接进行。
显微试剂和试剂盒
用于对微生物进行染色以便在显微镜下区分和鉴定微生物。如革兰氏染色等的试验,可提供进一步的生化、结构和形态信息。
微生物检测试剂盒
检测试剂盒采用生化反应、免疫反应等不同的检测方法。结果可通过可见凝聚、颜色反应或浊度等进行评估。
HybriScan® 原位杂交技术
HybriScan®高级微生物鉴定系统可利用分子生物学试验快速准确地检测和鉴定饮料、水和食品中的腐败和病原性微生物。主要基于探针标记的原位杂交技术。这种微孔板形式的可靠系统,不同于PCR检测,无需配备热循环仪。
圆片、试纸条和鉴定膜片
圆片、试纸条和鉴定膜片等都是便捷易用、基于生化试剂和反应的微生物鉴定试验用品。试验试剂浸渍在纸等载体上,性能稳定且易于操作。如用于检测细胞色素氧化酶活性的氧化酶试纸条。
常用分类
Products
Compare
Product Number
Product Name
Product Description
Pricing
产品亮点
20分钟的网络研讨会:原位杂交技术
了解HybriScan®检测方法相对于普通方法的优缺点和成本差异。
登录以继续。
如要继续阅读,请登录或创建帐户。
暂无帐户?